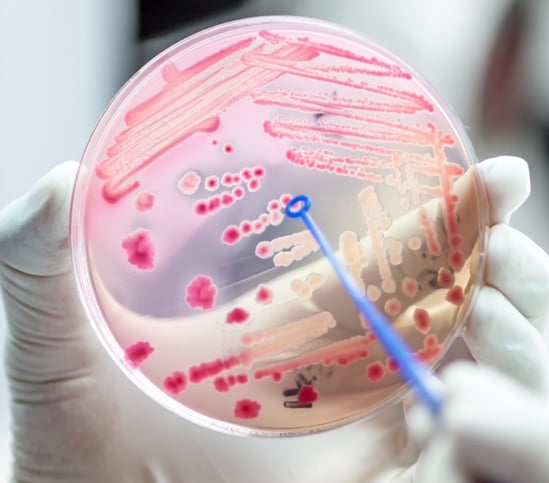

Le microplastiche, ovvero piccoli frammenti di detriti di plastica, sono ormai ovunque sul pianeta. Si sono infilate nelle catene alimentari, accumulate negli oceani, raggruppate in nuvole e sulle montagne, infine sono state trovate nei nostri corpi in quantità allarmanti. Comincia con queste osservazioni il resoconto di una ricerca tesa a dimostrare che probabilmente le microplastiche alimentano la resistenza agli antibiotici, una piaga sempre più incombente sulla salute di tutti. La ricerca, pubblicata su Applied and Environmental Microbiology, è stata condotta da un gruppo di studiosi della Boston University (USA) che con sorpresa hanno scoperto che batteri esposti a microplastiche diventano resistenti a molti tipi di antibiotici. Aggiungono che questo accade soprattutto in aree ad alta densità umana e di grande povertà tipo gli insediamenti di rifugiati dove si accatastano mucchi di plastica scartata e le infezioni batteriche si diffondono rapidamente.
OGNI ANNO MUOIONO 5 MILIONI PER INFEZIONI CURABILI
«Il fatto che ci siano microplastiche tutto intorno a noi, e ben di più nelle aree degradate dove le condizioni igienico-sanitarie non sono certo al massimo, è quel che più colpisce nelle nostre osservazioni», ha commentato Muhammad Zaman, professore di Ingegneria biomedica all’Università di Boston che studia la resistenza antimicrobica (anche dei farmaci antivirali) e la salute di rifugiati e migranti. Si calcola che ogni anno muoiano 4,95 milioni di persone per infezioni che la resistenza antimicrobica ha impedito di curare. I batteri, per esempio, diventano resistenti agli antibiotici per vari motivi legati a un utilizzo sbagliato e lo vedremo di seguito. Ma nel caso delle microplastiche il processo è specifico quanto sorprendente.
I BATTERI CREANO UN BIOFILM “PROTETTIVO”
Conta molto il microambiente, la stretta vicinanza di un microbo, dove i batteri e i virus si moltiplicano. Nel laboratorio del professor Zaman i ricercatori hanno fatto una prova rigorosa su come un comune batterio, l’Escherichia coli (un batterio che fa parte del nostro microbiota intestinale), reagisce se chiuso in un microambiente con microplastiche. «Le plastiche creano una superficie che i batteri attaccano e colonizzano – spiega Neila Gross, prima autrice della ricerca. – Riescono a coprire la superficie con un biofilm, una sostanza appiccicosa che agisce come uno scudo, proteggendo i batteri da eventuali invasori. Le microplastiche, poi, sovraccaricano queste pellicole biologiche talmente tanto che quando a questo miscuglio vengono aggiunti gli antibiotici, semplicemente questi non riescono a perforare lo scudo». Una resistenza “meccanica”, dunque.
IL VETRO RISULTA MENO “RESISTENTE”
Continua la dottoressa Gross: «Abbiamo constatato che i biofilm sulle microplastiche, in confronto ad altre superfici tipo il vetro, sono molto più forti e più appiccicati. Una cosa perfino scioccante da vedere». Il livello di resistenza agli antibiotici sulle microplastiche risultava così alto rispetto ad altri materiali che la ricercatrice è stata indotta a ripetere l’esperimento più volte, con diverse combinazioni di tipi di antibiotico e di tipo di plastiche. Ma i risultati erano sempre gli stessi. «Stiamo dimostrando – dichiara Zaman – che la presenza di plastiche fa molto di più che offrire una superficie dove i batteri si possono attaccare: in realtà stanno portando allo sviluppo di organismi resistenti».
GLI SFOLLATI PER FORZA SONO 122 MILIONI
Il professore dirige il Center on Forced Displacement che ha la missione di migliorare la situazione di quanti vengono forzatamente sfollati, tipo rifugiati e richiedenti asilo. Nel 2024 questa popolazione svantaggiata è stata calcolata in 122 milioni e risulta che le condizioni di salute tra loro sono spesso precarie. Ora, agli altri rischi del sovraffollamento e delle scarse risorse sanitarie, sembra aggiungersi il pericolo di contrarre infezioni resistenti alle cure. Osserva il professor Zaman: «Storicamente l’antibiotico-resistenza è stata legata al comportamento del paziente, a un suo non prendere l’antibiotico secondo la prescrizione medica. Ma non è colpa di una persona se viene costretta a vivere in un particolare ambiente, ed è un fatto che così si trova più esposta a contrarre infezioni resistenti. Ecco perché le cause ambientali e sociali dei superbatteri che non rispondono ai farmaci non possono venire ignorate».
UNO SCHIAFFO ALLA PENICILLINA NATA NEL 1928
A prescindere dalle microplastiche, l’antibiotico-resistenza, come abbiamo accennato, è un problema grave e in espansione: si torna a morire per infezioni che dall’invenzione in poi della penicillina (1928) erano diventate curabilissime, inglobando anche polmoniti batteriche e tubercolosi.
Ma come è nata e prospera questa “sconfitta” di una categoria di farmaci che hanno cambiato la medicina? Ne parliamo con la professoressa Alessandra Bandera, direttrice della Struttura complessa Malattie infettive del Policlinico di Milano.
COME NASCE IL NO AGLI ANTIBIOTICI
Una delle principali cause dell'antibiotico-resistenza è l’uso eccessivo e inappropriato di questi farmaci. Spesso gli antibiotici vengono assunti senza prescrizione medica, oppure vengono usati per trattare infezioni virali — come l'influenza o il raffreddore — contro cui sono del tutto inefficaci. Questo abuso favorisce la selezione naturale: i batteri sensibili vengono eliminati, mentre quelli che possiedono mutazioni resistenti sopravvivono, si moltiplicano e si diffondono. Non sono i batteri a "diventare più forti", ma è l’ambiente ricco di antibiotici a selezionare i più resistenti, dando loro un vantaggio evolutivo. Un'altra via importante è la trasmissione: i batteri resistenti possono diffondersi da persona a persona o attraverso l’ambiente, senza bisogno di contatto diretto. Gli ospedali, per esempio, rappresentano un ambiente ad alto rischio di trasmissione, soprattutto tra pazienti fragili e immunodepressi.
IL PRIMATO NEGATIVO DELL’ITALIA
«Purtroppo l’Italia è il primo paese in Europa per numero di morti legate all’antibiotico-resistenza – afferma la professoressa Bandera –. Dei circa 33.000 decessi annui che si registrano nell’Unione Europea per infezioni da batteri resistenti, oltre 10.000 avvengono nel nostro Paese». E il problema non si limita alle infezioni comuni, aggiunge l’infettivologa: «Molti dei progressi della medicina moderna si basano sulla disponibilità di antibiotici efficaci: interventi chirurgici complessi, impianto di protesi articolari o vascolari, trapianti d’organo, trattamenti oncologici e la gestione di patologie croniche come il diabete, l’asma o l’artrite reumatoide sarebbero molto più rischiosi senza la possibilità di prevenire o curare le infezioni».